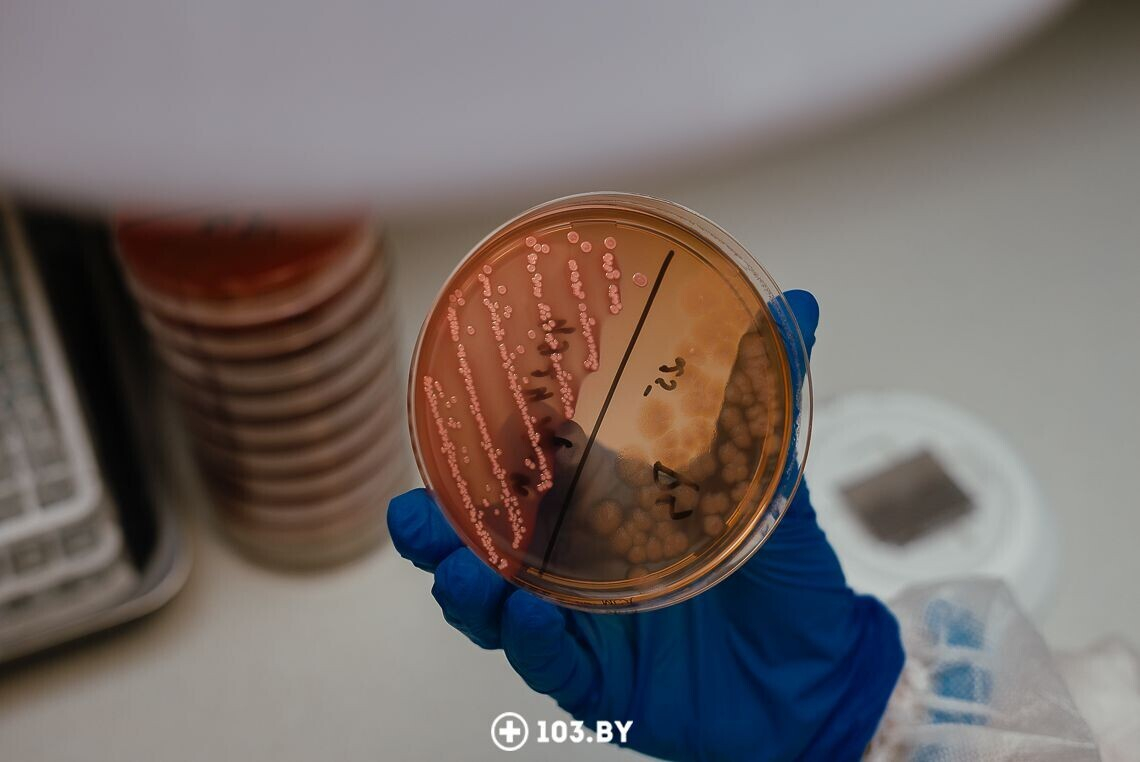

Директор «Хеликс» о ребрендинге: «Мы оставили лучшее от «Синэво», но намерены активно развиваться»
Одна из крупнейших частных лабораторий в Беларуси «Синэво» в феврале этого года перешла под крыло нового учредителя — международной компании «Хеликс». Процесс ребрендинга завершился в августе.
«Хеликс» достаточно хорошо известна на российском рынке. Под этим брендом работает более 600 диагностических центров и лабораторных пунктов в 200 городах России, есть они и в Казахстане. Компания первой в СНГ получила международный сертификат стандартов качества лабораторной диагностики CAP (The College of American Pathologists).
При этом белорусское представительство решило сохранить оборудование, систему сбора анализов, их логистику и обработку. Однако, по словам директора международной лаборатории «Хеликс», кандидата биологических наук Юлии Гуляевой, главное — компании удалось cохранить команду специалистов, начиная от медицинских сестер, заканчивая топ-менеджментом.

директор международной лаборатории «Хеликс»
— Мы очень благодарны «Синэво», потому что ее сформировали люди, которые работают в компании и которые продолжают здесь трудиться. Во время перехода под управление нового собственника нужно было решить: либо мы, образно говоря, все вместе беремся за руки и вместе идем в будущее, либо из-за сомнений и неуверенности теряем сплоченный и профессиональный коллектив. Естественно, сделали все, чтобы проигрался именно первый вариант. И у нас получилось. Могу сказать, что нам удалось не только сохранить, но и приумножить преимущества «Синэво».
Признательны «Хеликс», которая взяла нас под свое крыло, потому что их главная цель и задача — сохранить качество, привычный сервис, шаговую доступность, в общем, все то, что было наработано. Они были приятно удивлены нашим уровнем. Все изменения вводятся бережно, чтобы сделать лучше и оптимизировать уже существующую систему работы.
Одно из нововведений, которое имеет место — увеличение перечня лабораторных анализов — это позволило дополнить наше портфолио, расширить возможности для клиентов лаборатории. Однако, если подытожить, у нас фактически ничего не изменилось, кроме наименования юридического лица.

Какие главные принципы работы лаборатории на новом этапе вы бы выделили?
— Первый принцип — это качество и стандарты. Компания их четко придерживается и соблюдает, начиная со стандартов белорусского регулятора, заканчивая международными независимыми контролями качества.
Второй очень важный пункт — наша команда. Сначала обучить, а потом сохранить кадры. Ведь именно от людей зависит развитие и жизнь компании. И то лучшее, что у нас есть, это их прямая заслуга.
Третий принцип — работать во благо. Наша деятельность связана с очень важной функцией помощи людям.

Вы говорили, что сохранилась система взятия анализов, их расшифровки. Она достаточно серьезно автоматизирована. Расскажите об этом подробнее, пожалуйста.
— ПО, с которым мы работаем, называется ЛИС (лабораторная информационная система). Эта система позволяет присваивать анализам уникальные штрих-коды. Они печатаются на специальных этикетках. Когда клиент приходит на пункт и оформляет заказ, ему присваивается уникальный штрих-код, который больше нигде не повторяется. Далее данная этикетка при клиенте наклеивается на его пробирку со взятым биоматериалом.

Штрих-код при приеме в лабораторию считывается специальным оборудованием и проходит этап сортировки, после чего пробирка оказывается в аппарате для проведения анализов.

Готовые значения, которые выдали аппараты, еще раз проверяются врачом, чтобы получился максимально корректный результат. Если специалист видит, что показатели сильно отличаются от средних, либо его что-то смущает в полученных цифрах, пробирку могут отправить на повторное проведение анализа, либо врач может рекомендовать клиенту перезабор биоматериала.

Если же вся картина у специалиста складывается, он валидирует результат, и на почту клиенту отправляют заключение-расшифровку анализов.
У «Синэво» была собрана достаточно большая база с клиентской информацией. Как в «Хеликс» защищают личные данные?
— Здесь все очень прозрачно и понятно. В Беларуси весь процесс хранения подобной информации достаточно жестко регулируется законодательством. Одно из требований — чтобы базы данных, серверы территориально, физически располагались в стране. Плюс к этому процесс курируется государственными организациями, которые отвечают за хранение и безопасность цифровой информации. Поэтому все клиентские персональные данные находятся под защитой и контролем.

В Минске летом открылись два новых лабораторных пункта (на пр. Дзержинского и Партизанском пр.), компания приросла медработниками. Расширение — часть стратегии бренда?
— Да, это так. Речь не только о белорусском рынке, компания также работает в России и Казахстане. Несмотря на то, что в этих трех странах разные законодательства, бренд во всех случаях нацелен на развитие. Речь в том числе и об открытии новых пунктов для взятия анализов. Это создает дополнительный комфорт для клиентов, делает процесс оказания услуг более удобным.

Лабораторная служба «Хеликс» первой в СНГ прошла аккредитацию CAP (The College of American Pathologists). Как с сертификацией обстоят дела у белорусской лаборатории?
— У нас есть как белорусская аккредитация, так и международные сертификации: ISO 9001 (для документации) и ISO 15189 (по лабораторным исследованиям).
Что касается международных сертификатов, которые получила компания «Хеликс», мы ими тоже гордимся. Эти документы после тщательной проверки и контроля рабочего процесса выдают независимые международные эксперты.
Аккредитацию CAP «Хеликс» нужно будет подтверждать в следующем году. У нас договоренность и намерения присоединиться к процессу расширения сертификации в компании.

Как удается поддерживать на уровне качество оказания услуг?
— Мы используем в работе оборудование, оригинальные реагенты и расходные материалы ведущих мировых производителей, которым доверяем.
Качество, естественно, сильно зависит и от профессионализма, уровня знаний наших коллег, стараемся его непрерывно повышать. К примеру, у нас есть своя «Школа медсестры». Все медсестры, которые работают на пунктах сбора анализов нашей лабораторной службы, ее проходят. Обучение состоит из нескольких модулей, для передачи опыта мы привлекаем и специалистов извне. Тесно сотрудничаем с медиками службы неотложной помощи, которые обучают наших работников.
В обучающей программе, к примеру, есть модуль «Как работать со сложными ситуациями». Нужно понимать, что клиенты бывают разные. Кто-то, к примеру, может во время сдачи анализа крови потерять сознание. Наши сотрудники должны правильно действовать в таких ситуациях. Или возьмем работу с детьми — это вообще отдельная тема.
Какие планы у «Хеликс» на перспективу?
— Хотелось бы еще больше расширить панель выполняемых тестов и анализов. Но самая главная задача — работать на качество и развитие. Стоять на месте не получится: либо двигаться вперед, либо откатываться назад. Мы хотим сохранить наработанное и те лидерские позиции, признание клиентов, которые у нас сегодня уже есть. Для нас важно оправдать доверие и в дальнейшем, развиваясь и выполняя свою работу максимально профессионально.
Фото: Анна Занкович
ООО «Международная лаборатория Хеликс», УНП 191119686